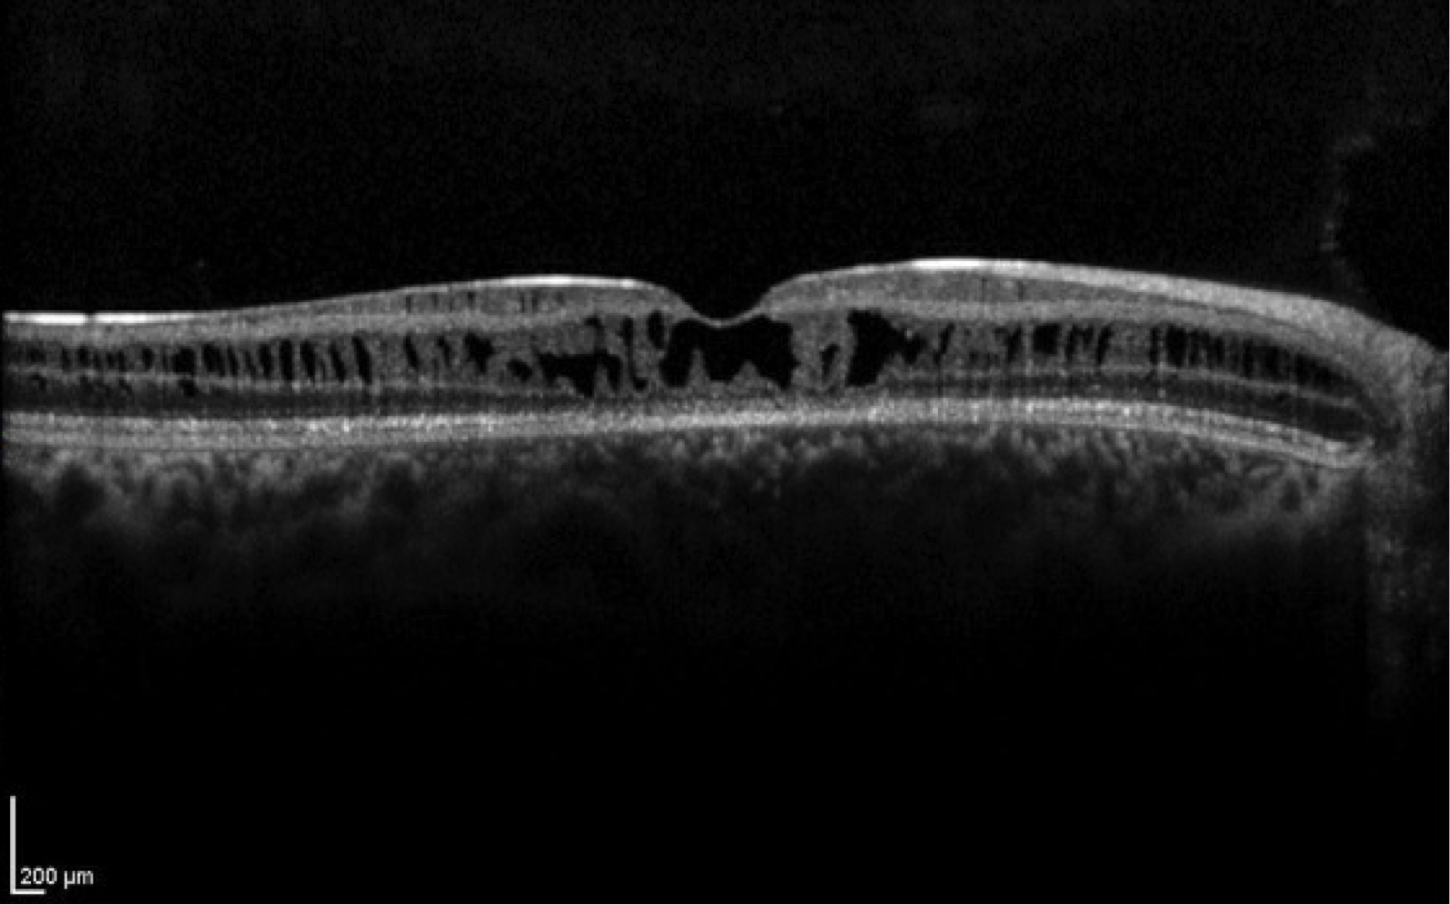

Big 14 Self-Assessment
Case 14
Case 14 is an 11 year old male with 20/60 vision. His parents have normal vision but he has a brother with reduced acuity. Fundus examination reveals normal disks and vessels, but there is a stellate arrangement of cysts centered on the fovea.